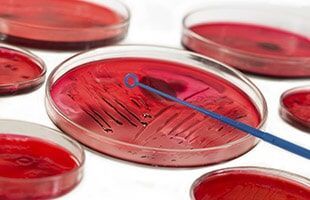

Covid Spot
PCR TEST
ΜΟΡΙΑΚΟ ΤΕΣΤ ΚΟΡΩΝΟΪΟΥ
RAPID TEST
RAPID TEST ΑΝΤΙΓΟΝΟΥ
ΤΕΣΤ ΑΝΤΙΣΩΜΑΤΩΝ
ΑΝΤΙΣΩΜΑΤΑ ΕΝΑΝΤΙ ΚΟΡΩΝΟΪΟΥ IgG / Ig
ΕΛΕΓΧΟΣ ΑΛΛΕΡΓΙΟΓΟΝΩΝ
ΕΛΕΓΧΟΣ ΑΛΛΕΡΓΙΟΓΟΝΩΝ ΓΙΑ ΕΜΒΟΛΙΑ COVID - 19
(PFIZER, MODERNA, ASTRA ZENECA, JOHNSON & JOHNSON)
Αιμοληψία κατ’ οίκον
Παρέχεται η δυνατότητα αιμοληψίας κατ’ οίκον, μετά από συνεννόηση, σε κλινήρη ή υπέργηρα άτομα που αντιμετωπίζουν δυσκολία μετακίνησης.
Αιμοληψίες σε βρέφη, παιδιά και εφήβους
Λόγω πολυετούς εμπειρίας της ιατρού, η αιμοληψία στους μικρούς μας φίλους παρέχεται με τον πιο ανώδυνο τρόπο σε ένα ευχάριστο φιλικό περιβάλλον.
Πιστοποίηση ISO 9001 :2008
Το ιατρείο είναι πιστοποιημένο σύμφωνα με το σύστημα διαχείρισης ποιότητας ΕΛΟΤ ΕΝ ISO 9001:2008.
Ωράριο λειτουργίας
Δευτέρα 07:00 - 15:00
Τρίτη 07:00 - 15:00
18:00 - 20:00
Τετάρτη 07:00 - 15:00
Πέμπτη 07:00 - 15:00
18:00 - 20:00
Παρασκευή 07:00 - 15:00
Σάββατο Κατόπιν Ραντεβού
Κυριακή Κλειστά
Μικροβιολογικό Διαγνωστικό Ιατρείο Προνοώ στα Σεπόλια, Αθήνα
Ποιοι Είμαστε
Το Μικροβιολογικό διαγνωστικό ιατρείο «ΠΡΟΝΟΩ» ιδρύθηκε το 1992 από την ιατρό Μικροβιολόγο - Βιοπαθολόγο Δήμητρα Παπαλάμπρου, διδάκτορα του Πανεπιστημίου Αθηνών και λειτουργεί σε ιδιόκτητο νεοκλασικό κτίριο στην Αγ. Μελετίου 194 (πλησίον μετρό Αττικής, Σεπόλια). Η πρόσβαση στον χώρο μας είναι εύκολη, χωρίς ταλαιπωρία με όλα τα μέσα μαζικής μεταφοράς (μετρό, λεωφορεία, τρόλεϊ).
Το «Προνοώ» με αίσθημα ευθύνης προς τον εξεταζόμενο συνάνθρωπο μας, αλλά και στον παραπέμποντα συνάδελφο ιατρό, παρέχει ιατρικές υπηρεσίες υψηλών προδιαγραφών στα πλαίσια της πρωτοβάθμιας φροντίδας υγείας.
Διαθέτει σύγχρονο τεχνολογικό εξοπλισμό (αναλυτές γνωστών εταιριών BIOMERIEUX, MENARINI, SYSMEX MEGALAB) και απασχολεί τεχνολόγους ανώτερης πανεπιστημιακής εκπαίδευσης (ΤΕΙ ΑΘΗΝΑΣ) με εμπειρία, ευγένεια και ήθος.
Για τη διασφάλιση της ποιότητας εφαρμόζει καθημερινά
εσωτερικό ποιοτικό έλεγχο,
συμμετέχει σε εξωτερικούς ποιοτικούς ελέγχους από παγκοσμίως αναγνωρισμένους φορείς και διαθέτει σύστημα μηχανογράφησης συνδεδεμένο “on line” με τους αναλυτές για την ασφαλέστερη απ’ ευθείας μεταφορά και αποθήκευση των αποτελεσμάτων.
Το Διαγνωστικό ιατρείο Προνοώ, είναι μέλος του δικτύου
Iatrica, του πρωτοπόρου Πανελλαδικού Δίκτυου Διαγνωστικών Ιατρείων Πιστοποιημένης Ποιότητας, με πάνω από 170 ιατρεία σε όλη την Ελλάδα, που λειτουργεί με γνώμονα το επιστημονικό κύρος και την ποιοτική εξυπηρέτηση.
Η Ιατρός
Η άρτια επιστημονική κατάρτιση της ιατρού Μικροβιολόγου - Βιοπαθολόγου Δήμητρας Παπαλάμπρου, η διαρκής παρουσία της στο χώρο του ιατρείου και η συνεχής ενημέρωσή της σε ιατρικά θέματα, σε συνδυασμό με το εξειδικευμένο προσωπικό και τον εξοπλισμό του εργαστηρίου αποτελούν εγγύηση για την ΕΓΚΥΡΟΤΗΤΑ & ΑΞΙΟΠΙΣΤΙΑ των αποτελεσμάτων.